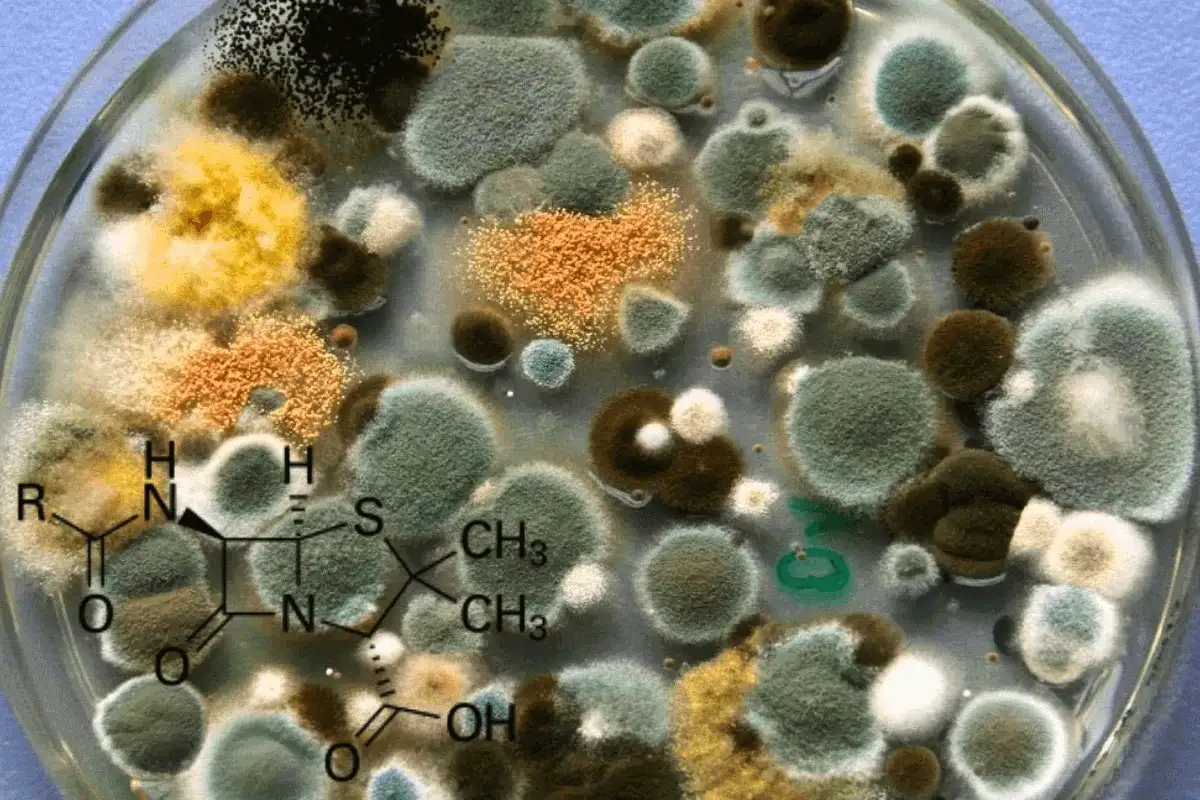
Voiko home vallata planeetan? Totuus näiden sitkeiden sienten voimasta

Oletko koskaan miettinyt, voisiko home – tuo leipään ilmestyvä kutsumaton vieras – todella ottaa vallan maailmasta? Home ei ole vain keittiön riesa, vaan äärimmäisen sitkeä organismi, joka selviää jopa ankarimmissa oloissa ja pitää yllä planeetan ekosysteemejä. Voiko home vallata planeetan? Tämä artikkeli sukeltaa homeen uskomattomiin kykyihin, sen rooliin luonnossa ja siihen, miksi sen maailmanvalloitus ei ole vielä nurkan takana. Valmiina? Aloitetaan!
Homeen supervoimat: Miten se muokkaa planeettaamme?
Home ei ole pelkkä pilaantuneen ruoan merkki – se on ekosysteemien sankari, joka on muokannut maapalloa miljoonia vuosia. Noin 450 miljoonaa vuotta sitten homeen kaltaiset sienet auttoivat kasveja siirtymään kuivalle maalle luomalla ensimmäisiä maaperiä. Vaikka home ei muodosta mykorritsaa, se hajottaa kuollutta orgaanista ainesta, kuten lehtiä, vapauttaen ravinteita, kuten fosforia ja typpeä, jotka ovat elintärkeitä kasveille.
Luonnonkatastrofien, kuten metsäpalojen, jälkeen home on ensimmäinen, joka asuttaa tuhoutuneen alueen. Se pitää maaperän ravinteet paikoillaan ja valmistelee maata kasvien paluulle. Tämä tekee homesta korvaamattoman osan luonnon kiertokulkua. Ajattele hetki: ilman homeen kaltaisia sieniä ekosysteemimme olisivat hyvin erilaisia.
- Ravinnekierto: Home vapauttaa ravinteita, joita kasvit tarvitsevat kasvaakseen.
- Ekosysteemin palautuminen: Se aloittaa toipumisen katastrofien jälkeen.
- Sitkeys: Home selviää siellä, missä muut organismit luovuttavat.
Haluatko nähdä homeen toiminnassa? Tarkista seuraavan kerran ulkona kaatunut puu – home on jo työssään!
Homeen uskomaton selviytyminen: Antarktiksesta avaruuteen
Voiko home vallata planeetan? Sen selviytymiskyky herättää kunnioitusta. Home on löydetty Antarktiksella, missä lämpötilat laskevat alle -80 °C, ja se kukoistaa niukassa ravinnossa. Tshernobylin ydinvoimalassa tutkijat havaitsivat homeen, joka ei vain selvinnyt säteilyssä, vaan kasvoi nopeammin melaniinipigmentin avulla, joka hyötyy ionisoivasta säteilystä.
Vuonna 2019 kokeet osoittivat, että homesienet kestivät avaruuden kaltaisia olosuhteita, kuten sadan kertaa ihmiselle tappavaa röntgensäteilyä. Niitä on löydetty myös Kansainväliseltä avaruusasemalta (ISS). Tämä sitkeys osoittaa, että home voi mukautua lähes mihin tahansa – mutta onko se uhka?
- Ääriolosuhteet: Home selviää kylmässä, kuumassa ja säteilyssä.
- Melaniinin voima: Säteily voi jopa kiihdyttää sen kasvua.
- Avaruuselämää: Home on osoittanut selviytyvänsä avaruuden kaltaisissa oloissa.
Seuraavan kerran, kun näet homepilkun, mieti: tämä pieni organismi voisi selviytyä Marsissa!
Homeen uhkat: Miksi se voi olla vaarallinen?
Vaikka home on luonnon sankari, se voi olla myös uhka. Voiko home vallata planeetan? Ilmastonmuutos luo sille ihanteellisia oloja: lämpö, kosteus ja ravinteet lisäävät sen aktiivisuutta. Tämä voi johtaa viljasatojen pilaantumiseen ja elintarvikepulaan, sillä home tuhoaa viljaa nopeasti kosteissa oloissa.
Rakennuksissa musta home on erityisen pelätty. Se tuottaa mikotoksiineja, jotka voivat aiheuttaa allergioita, astmaa ja jopa neurologisia ongelmia. Viimeisen vuosikymmenen aikana mustan homeen aiheuttamat kuolemat ovat kaksinkertaistuneet, mikä korostaa sen vaaroja. Kosteissa kodeissa home leviää helposti, heikentäen terveyttä ja rakenteita.
- Viljasadot: Home voi tuhota varastoja, uhkaen ruokaturvaa.
- Terveysriskit: Musta home aiheuttaa hengitysongelmia ja allergioita.
- Rakennukset: Kosteus ruokkii homeen kasvua, vahingoittaen seiniä.
Tarkista kotisi kosteat nurkat tänään – pieni ennaltaehkäisy voi säästää paljon vaivaa.
Mikä pitää homeen kurissa? Luonnon ja ihmisen torjuntakeinot
Vaikka home on sitkeä, se ei ole voittamaton. Luonnossa bakteerit, kuten aktinobakteerit, tuottavat aineita, jotka hidastavat homeen kasvua ja kilpailevat ravinteista. Ihmisetkin ovat kehittäneet keinoja: antimikrobiset maalit hopeananopartikkeleilla estävät homeen leviämistä rakennuksissa, ja biologiset fungisidit suojaavat satoja.
Voiko home vallata planeetan? Tuskin, sillä luonto ja teknologia pitävät sen aisoissa. Home on kuitenkin jo “vallannut” planeetan siinä mielessä, että se on keskeinen osa ekosysteemiä. Vaikka se ei muutu The Last of Us -tyyliseksi uhaksi, sen vaikutus terveyteen ja ympäristöön muistuttaa, että tasapaino on tärkeää.
Ota askel kohti turvallisempaa arkea: tarkista jääkaappisi ja kodin nurkat homeen varalta. Jos haluat sukeltaa syvemmälle, tutki, miten home vaikuttaa lähiympäristöösi – saatat yllättää itsesi! Mikä homeen piirre kiehtoo sinua eniten? Jaa kommenteissa ja inspiroi muita – yhdessä pidämme planeetan tasapainossa!